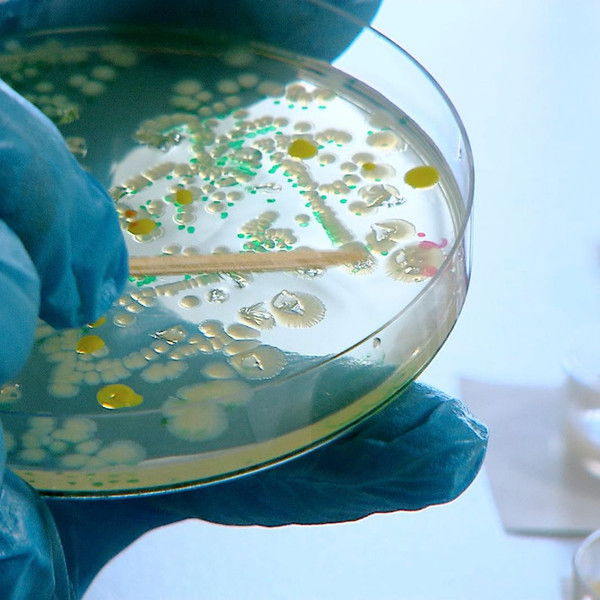
Killer-Keime - Gefahr aus dem Tierstall

Killer-Keime - Gefahr aus dem Tierstall (2014)
Play Trailer
Overview
Animals in factory farming are susceptible to disease. This is why antibiotics are used. This massive use leads to the development of more and more germs that become resistant to antibiotics. This means that even more antibiotics have to be administered. A vicious circle. Antibiotics and resistant germs also reach humans through the consumption of meat. In the event of illness, or even an emergency, it is becoming increasingly difficult for doctors to find medication for patients, as widespread resistance has already developed.